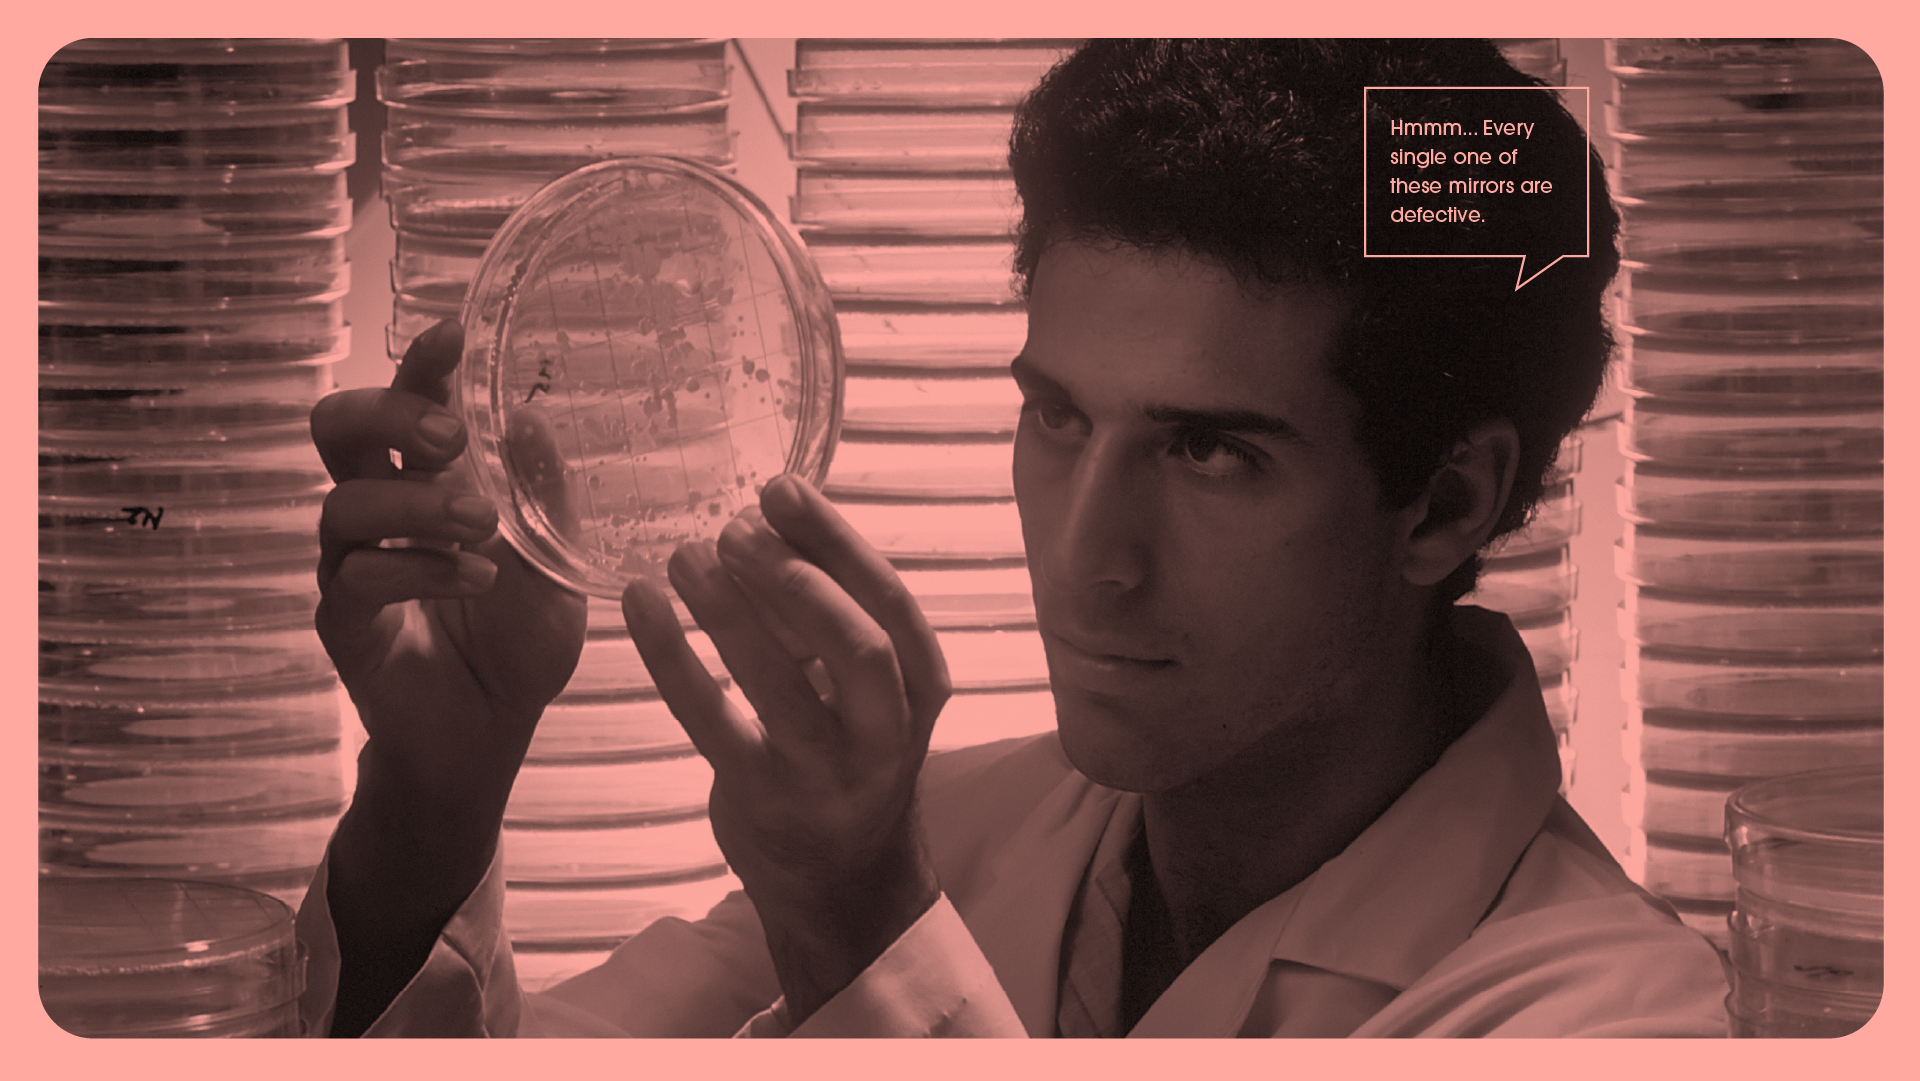
Pink splash page for Lab‑ish featuring a man studying petri dishes with a joke quote bubble, used as a playful pacing break in the guide.

Lab-ish
Logo Design + Brand Identity
Lab-ish is a quirky, science inspired ecommerce brand that transforms clinical laboratory life into clever, wearable humor. They blend scientific precision with nerdy wit to create apparel and accessories that resonate with lab professionals, science lovers, and anyone who appreciates a smart, science-themed punchline.
My role was to create a scalable typographic and pictorial logo suite that lent well to a set of lab inspired icons, patterns and brand assets suitable for timeless science fun embodied in a full brand identity and brand guide design.
From here, the client has a working set of brand assets to start their new ecommerce line with a confident voice, cohesive colors and a unique aesthetic angle to appeal to their audience within the scientific community.